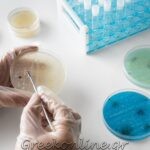

ΠΡΟΣΦΕΡΟΜΕΝΕΣ ΥΠΗΡΕΣΙΕΣ
ΜΙΚΡΟΒΙΟΛΟΓΟΣ – ΒΙΟΠΑΘΟΛΟΓΟΣ
ΜΙΚΡΟΒΙΟΛΟΓΙΚΟ ΕΡΓΑΣΤΗΡΙΟ
- ΒΙΟΧΗΜΙΚΟ ΕΡΓΑΣΤΗΡΙΟ
- ΟΡΜΟΝΟΛΟΓΙΚΟ ΕΡΓΑΣΤΗΡΙΟ – ΑΝΟΣΟΛΟΓΙΚΟ ΕΡΓΑΣΤΗΡΙΟ
- ΛΟΙΜΩΞΕΙΣ – ΕΛΕΓΧΟΣ ΑΝΑΠΝΕΥΣΤΙΚΩΝ ΝΟΣΗΜΑΤΩΝ
- ΑΞΙΟΛΟΓΗΣΗ ΕΡΓΑΣΤΗΡΙΑΚΩΝ ΕΞΕΤΑΣΕΩΝ
- ΓΕΝΙΚΕΣ ΜΙΚΡΟΒΙΟΛΟΓΙΚΕΣ – ΒΙΟΠΑΘΟΛΟΓΙΚΕΣ ΕΞΕΤΑΣΕΙΣ
- ΒΙΟΧΗΜΙΚΕΣ – ΑΙΜΑΤΟΛΟΓΙΚΕΣ – ΟΡΜΟΝΟΛΟΓΙΚΕΣ – ΑΝΟΣΟΛΟΓΙΚΕΣ ΕΞΕΤΑΣΕΙΣ
- ΠΑΡΑΣΙΤΟΛΟΓΙΚΕΣ – ΒΑΚΤΗΡΙΟΛΟΓΙΚΕΣ ΕΞΕΤΑΣΕΙΣ
- ΕΞΕΤΑΣΕΙΣ ΟΥΡΩΝ – ΕΞΕΤΑΣΕΙΣ ΑΙΜΑΤΟΣ
- ΣΥΜΒΕΒΛΗΜΕΝΗ ΜΕ ΕΟΠΥΥ